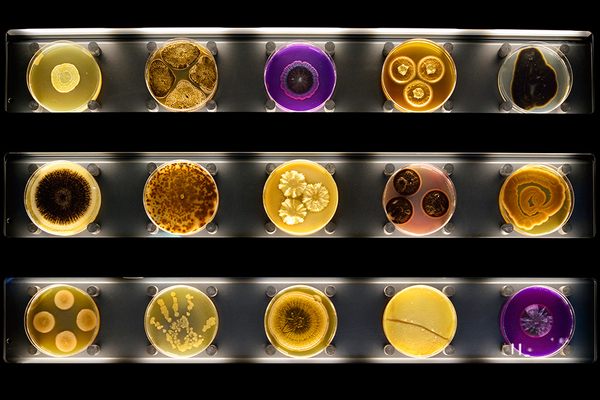

The Atlas Obscura Guide To Amsterdam
73 Cool, Hidden, and Unusual Things to Do in Amsterdam, Netherlands
Updated February 14, 2025
Unusual Attractions in Amsterdam
Cool Places to Eat & Drink in Amsterdam
In partnership with KAYAK
Plan Your Trip
In Partnership with GetYourGuide
Unforgettable Experiences Nearby
From red light secrets to cheese tastings to dike day trip and boat tours.
Discover ExperiencesAtlas Obscura Itineraries
Amsterdam
Forge your own path in this tourist magnet, toward places that are less crowded but no less wondrous.
%20%e2%80%93%20photo%20courtesy%20of%20mirjam%20bleeker_1.jpg)
Amsterdam Leaderboard
Recent Amsterdam Activity
-
wants to go to Huddesteen
-
wants to go to Cuypers Library
-
wants to go to Café De Dokter
-
updated Bijbels Museum

.jpg)

